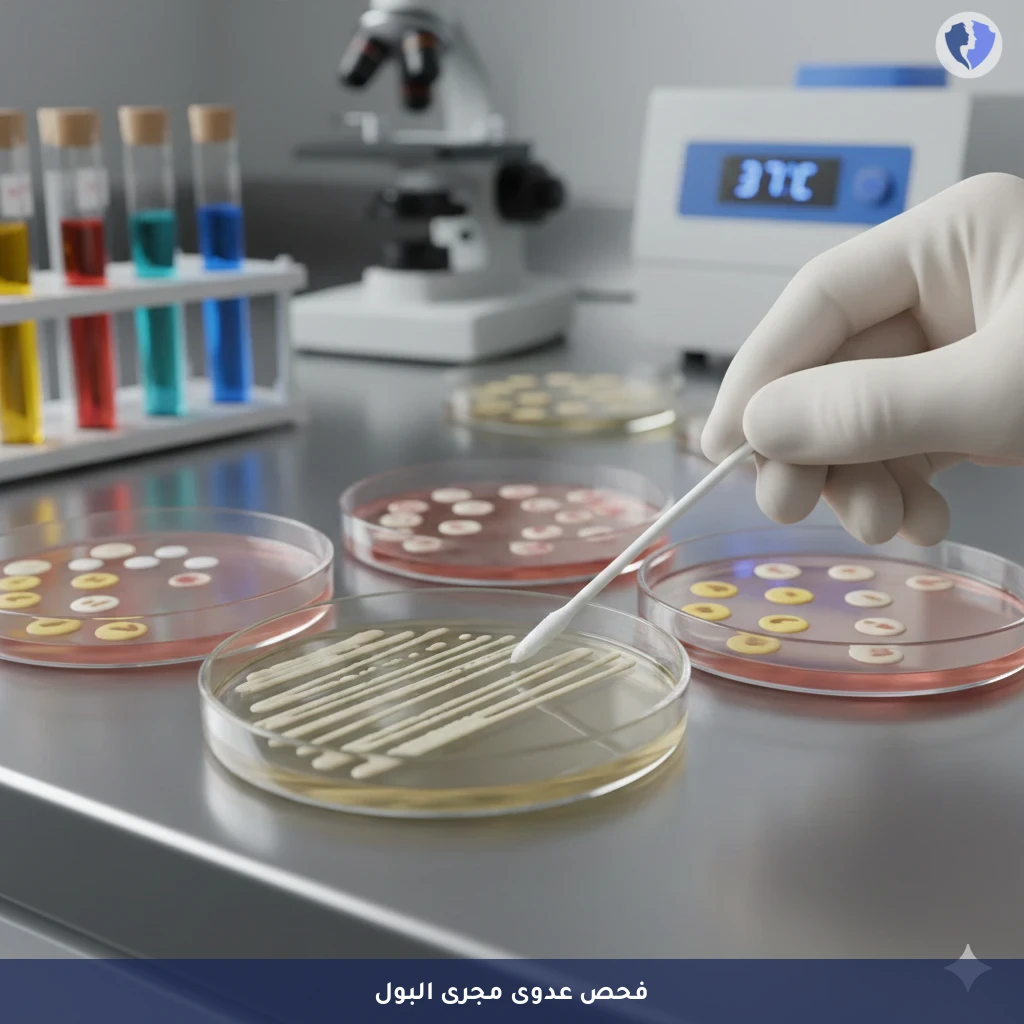
مزرعة مسحة مجرى البول

تفاصيل الخدمة
مزرعة مسحة مجرى البول
فحص ميكروبيولوجي يتم فيه جمع عينة من داخل الإحليل (مجرى البول) باستخدام مسحة رفيعة ومعقمة خاصة. تهدف الزراعة إلى عزل وتحديد البكتيريا المسببة لالتهاب الإحليل (Urethritis)، والتي قد تشمل مسببات الأمراض المنقولة جنسياً (مثل Neisseria gonorrhoeae، Chlamydia trachomatis) أو بكتيريا أخرى (مثل E. coli، Enterococcus). بعد تحديد البكتيريا، يُجري اختبار الحساسية للمضادات الحيوية لتحديد العلاج الأمثل. وهو الفحص الأساسي لتشخيص التهاب الإحليل البكتيري، خاصة عند الذكور.